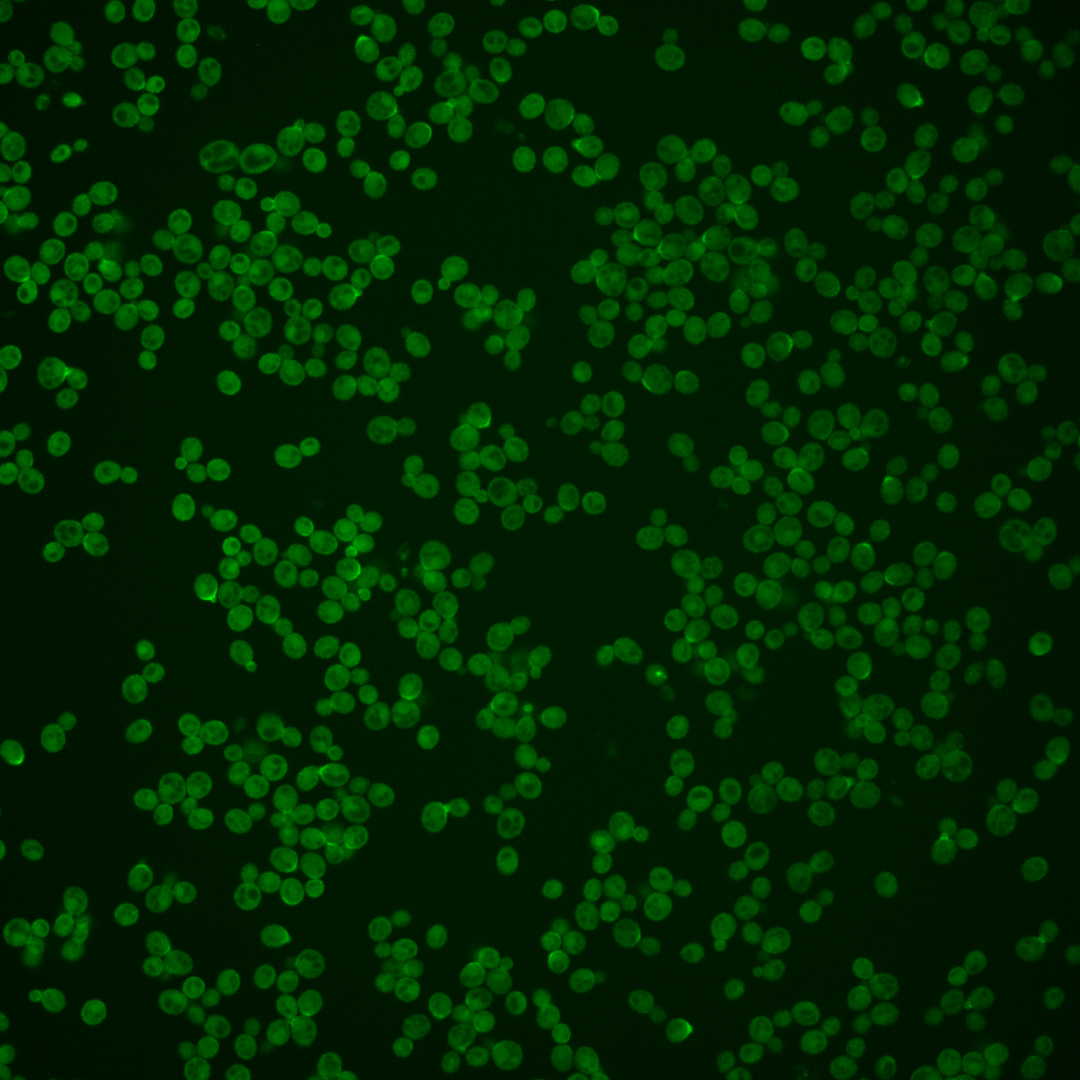
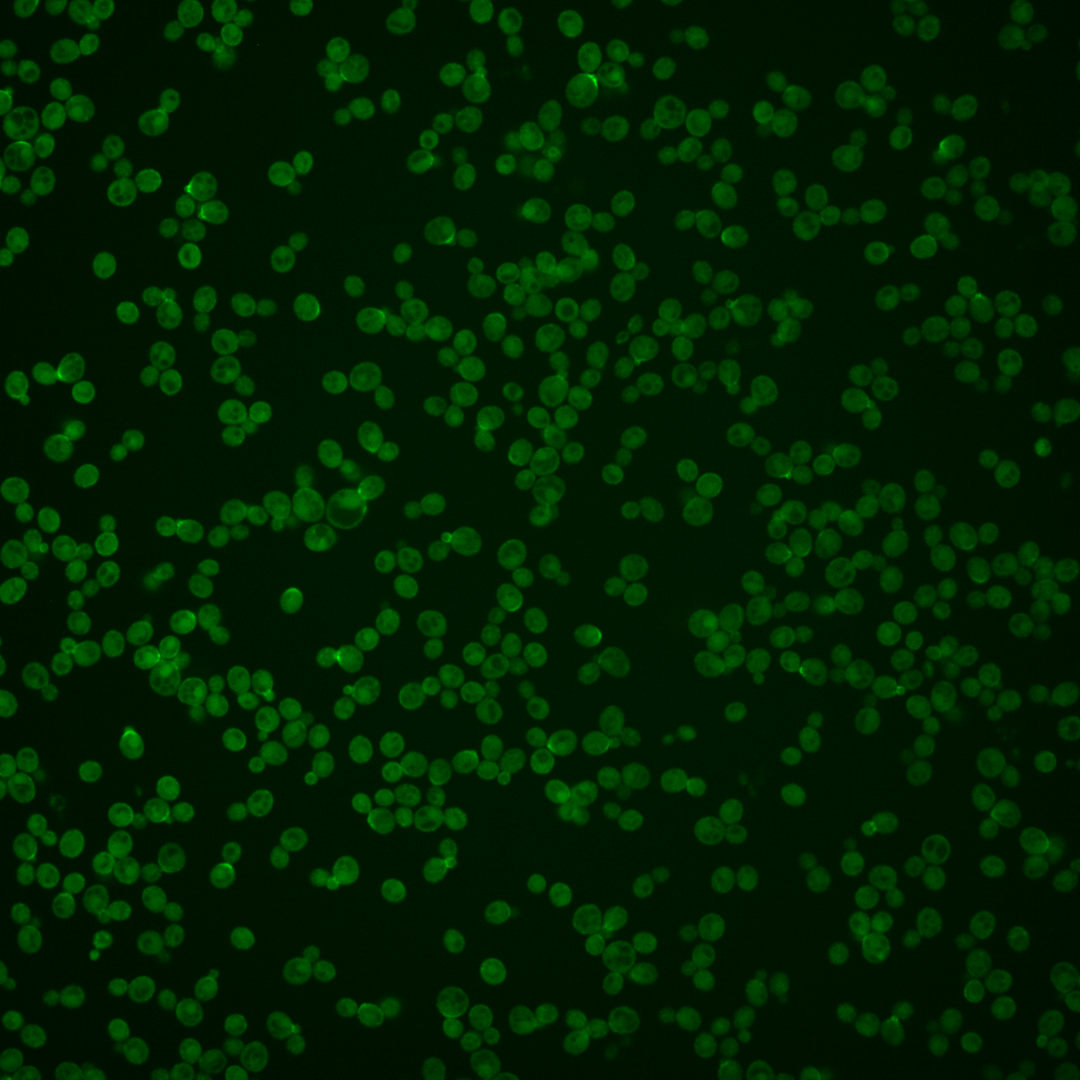
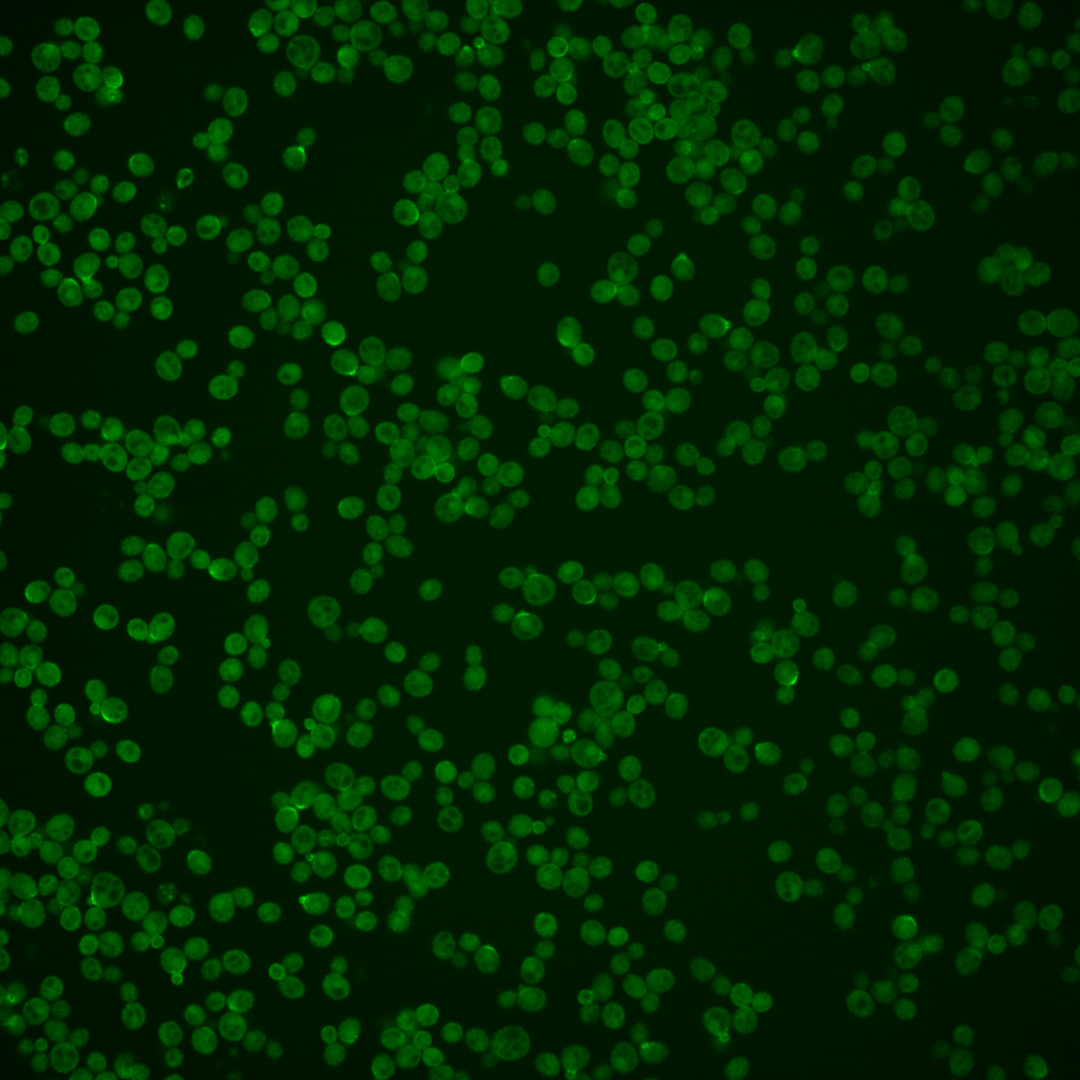

| Standard name | |
|---|---|
| Human Ortholog | |
| Description | Glucose-repressible ADP-ribosylation factor; GTPase of Ras superfamily involved in regulating cell polarity and invasive growth; localizes to dynamic spots at plasma membrane and modulates PtdIns(4,5)P2 levels to facilitate endocytosis; required for localization of endocytic protein Lsb5p to correct cortical site in cells; also has mRNA binding activity; homolog of mammalian Arf6 |
Micrographs




















































































Sub-cellular Localization
Yeast GFP Assignment
Protein Abundance
Localization Change
External localization resources
| ensLOC | DeepLoc | |||||||||||||||||||||||
|---|---|---|---|---|---|---|---|---|---|---|---|---|---|---|---|---|---|---|---|---|---|---|---|---|
| Localization | WT1 | WT2 | WT3 | RAP60 | RAP140 | RAP220 | RAP300 | RAP380 | RAP460 | RAP540 | RAP620 | RAP700 | HU80 | HU120 | HU160 | rpd3Δ_1 | rpd3Δ_2 | rpd3Δ_3 | WT1 | WT2 | WT3 | AF100 | AF140 | AF180 |
| Cortical Patches | 77 | 49 | 50 | 27 | 84 | 71 | 80 | 52 | 32 | 65 | 27 | 43 | – | 31 | 48 | 45 | 46 | 31 | 25 | 35 | 15 | 3 | 8 | 8 |
| Bud | 31 | 27 | 32 | 19 | 55 | 52 | 69 | 65 | 45 | 60 | 44 | 56 | – | 12 | 12 | 31 | 29 | 17 | 17 | 13 | 8 | 0 | 5 | 6 |
| Bud Neck | 1 | 0 | 0 | 1 | 1 | 0 | 0 | 0 | 0 | 0 | 0 | 0 | – | 0 | 0 | 1 | 7 | 0 | 53 | 65 | 26 | 9 | 9 | 16 |
| Bud Site | 18 | 11 | 9 | 6 | 17 | 9 | 17 | 5 | 2 | 8 | 6 | 8 | – | 6 | 9 | 23 | 16 | 10 | – | – | – | – | – | – |
| Cell Periphery | 168 | 103 | 77 | 102 | 84 | 154 | 197 | 131 | 166 | 165 | 160 | 198 | – | 52 | 82 | 33 | 42 | 49 | 162 | 78 | 81 | 29 | 38 | 48 |
| Cytoplasm | 91 | 90 | 49 | 112 | 141 | 178 | 315 | 299 | 248 | 341 | 294 | 334 | – | 39 | 60 | 97 | 58 | 76 | 18 | 35 | 8 | 5 | 7 | 17 |
| Endoplasmic Reticulum | 9 | 7 | 5 | 12 | 23 | 21 | 34 | 10 | 14 | 11 | 8 | 10 | – | 2 | 5 | 12 | 5 | 8 | 26 | 17 | 12 | 2 | 11 | 9 |
| Endosome | 0 | 1 | 1 | 5 | 6 | 0 | 3 | 11 | 2 | 7 | 11 | 4 | – | 0 | 9 | 7 | 11 | 12 | 1 | 1 | 1 | 0 | 0 | 0 |
| Golgi | 2 | 0 | 0 | 0 | 0 | 0 | 0 | 0 | 0 | 0 | 0 | 0 | – | 0 | 0 | 0 | 3 | 0 | 1 | 1 | 0 | 1 | 0 | 0 |
| Mitochondria | 0 | 0 | 2 | 0 | 1 | 13 | 38 | 46 | 35 | 53 | 42 | 73 | – | 0 | 0 | 10 | 6 | 6 | 1 | 0 | 1 | 1 | 1 | 0 |
| Nucleus | 0 | 2 | 0 | 0 | 1 | 1 | 3 | 6 | 1 | 2 | 1 | 2 | – | 0 | 1 | 9 | 5 | 3 | 0 | 0 | 0 | 0 | 0 | 0 |
| Nuclear Periphery | 0 | 0 | 0 | 0 | 0 | 0 | 2 | 17 | 1 | 1 | 3 | 1 | – | 0 | 0 | 0 | 0 | 0 | 0 | 0 | 0 | 0 | 0 | 0 |
| Nucleolus | 1 | 0 | 3 | 0 | 2 | 1 | 3 | 23 | 5 | 6 | 7 | 15 | – | 1 | 3 | 24 | 26 | 12 | 0 | 0 | 0 | 0 | 0 | 0 |
| Peroxisomes | 0 | 1 | 0 | 2 | 0 | 1 | 0 | 2 | 2 | 1 | 3 | 6 | – | 1 | 0 | 5 | 6 | 12 | 0 | 0 | 0 | 0 | 0 | 0 |
| SpindlePole | 2 | 3 | 6 | 11 | 11 | 2 | 5 | 10 | 6 | 19 | 14 | 30 | – | 3 | 14 | 74 | 69 | 68 | 0 | 0 | 2 | 0 | 0 | 2 |
| Vac/Vac Membrane | 0 | 2 | 3 | 4 | 8 | 3 | 23 | 29 | 16 | 28 | 16 | 13 | – | 0 | 8 | 14 | 14 | 10 | 2 | 3 | 0 | 2 | 0 | 0 |
| Unique Cell Count | 259 | 199 | 148 | 194 | 295 | 334 | 538 | 520 | 382 | 521 | 423 | 529 | 102 | 164 | 270 | 225 | 223 | 312 | 255 | 161 | 57 | 85 | 114 | |
| Labelled Cell Count | 400 | 296 | 237 | 301 | 434 | 506 | 789 | 706 | 575 | 767 | 636 | 793 | 147 | 251 | 385 | 343 | 314 | 312 | 255 | 161 | 57 | 85 | 114 | |
Yeast GFP Assignment
Protein Abundance
| Screen | WT1 | WT2 | WT3 | RAP60 | RAP140 | RAP220 | RAP300 | RAP380 | RAP460 | RAP540 | RAP620 | RAP700 | HU80 | HU120 | HU160 | rpd3Δ_1 | rpd3Δ_2 | rpd3Δ_3 | AF100 | AF140 | AF180 |
|---|---|---|---|---|---|---|---|---|---|---|---|---|---|---|---|---|---|---|---|---|---|
| Mean Cell GFP Intensity (1e-4) | 11.8 | 13.0 | 9.4 | 9.3 | 9.8 | 9.2 | 8.8 | 8.9 | 9.2 | 8.8 | 8.8 | 9.4 | – | 11.5 | 11.5 | 12.5 | 13.5 | 13.3 | 12.9 | 13.0 | 13.3 |
| Std Deviation (1e-4) | 2.4 | 2.3 | 1.8 | 1.9 | 2.0 | 1.8 | 2.0 | 2.1 | 2.2 | 2.1 | 2.1 | 2.4 | – | 1.7 | 2.0 | 3.7 | 3.9 | 3.8 | 2.4 | 2.4 | 2.4 |
| Intensity Change (Log2) | – | – | – | -0.02 | 0.06 | -0.02 | -0.09 | -0.07 | -0.02 | -0.09 | -0.1 | 0.01 | – | 0.3 | 0.3 | 0.42 | 0.53 | 0.5 | 0.46 | 0.48 | 0.51 |
Localization Change
| Localization | RAP60 | RAP140 | RAP220 | RAP300 | RAP380 | RAP460 | RAP540 | RAP620 | RAP700 | HU80 | HU120 | HU160 | rpd3Δ_1 | rpd3Δ_2 | rpd3Δ_3 |
|---|---|---|---|---|---|---|---|---|---|---|---|---|---|---|---|
| Cortical Patches | -4.4 | -1.1 | -2.9 | -5.2 | -7.1 | -7.3 | -6.1 | -8.4 | -8.0 | – | -0.6 | -0.9 | -4.0 | -2.9 | -4.5 |
| Bud | -3.0 | -0.7 | -1.6 | -2.7 | -2.8 | -2.9 | -3.2 | -3.5 | -3.5 | – | -2.0 | -3.6 | -2.8 | -2.2 | -3.9 |
| Bud Neck | 0 | 0 | 0 | 0 | 0 | 0 | 0 | 0 | 0 | – | 0 | 0 | 0 | 0 | 0 |
| Bud Site | -1.3 | -0.1 | -1.8 | -1.6 | 0 | 0 | 0 | 0 | 0 | – | -0.1 | -0.2 | 0.9 | 0.4 | -0.7 |
| Cell Periphery | 0.1 | -4.9 | -1.2 | -3.4 | -6.2 | -1.8 | -4.5 | -3.0 | -3.2 | – | -0.2 | -0.4 | -8.8 | -6.8 | -6.0 |
| Cytoplasm | 4.5 | 2.9 | 4.1 | 5.5 | 5.2 | 6.6 | 7.0 | 7.8 | 6.5 | – | 0.8 | 0.6 | 0.6 | -1.5 | 0.2 |
| Endoplasmic Reticulum | 1.2 | 1.8 | 1.3 | 1.4 | 0 | 0.2 | 0 | 0 | 0 | – | 0 | 0 | 0.5 | 0 | 0.1 |
| Endosome | 0 | 0 | 0 | 0 | 0 | 0 | 0 | 0 | 0 | – | 0 | 0 | 0 | 0 | 2.4 |
| Golgi | 0 | 0 | 0 | 0 | 0 | 0 | 0 | 0 | 0 | – | 0 | 0 | 0 | 0 | 0 |
| Mitochondria | 0 | 0 | 0 | 2.6 | 3.1 | 3.2 | 3.4 | 3.4 | 4.3 | – | 0 | 0 | 0 | 0 | 0 |
| Nucleus | 0 | 0 | 0 | 0 | 0 | 0 | 0 | 0 | 0 | – | 0 | 0 | 0 | 0 | 0 |
| Nuclear Periphery | 0 | 0 | 0 | 0 | 0 | 0 | 0 | 0 | 0 | – | 0 | 0 | 0 | 0 | 0 |
| Nucleolus | 0 | 0 | 0 | 0 | 1.3 | 0 | 0 | 0 | 0 | – | 0 | 0 | 2.7 | 3.4 | 1.6 |
| Peroxisomes | 0 | 0 | 0 | 0 | 0 | 0 | 0 | 0 | 0 | – | 0 | 0 | 0 | 0 | 0 |
| SpindlePole | 0.7 | -0.2 | 0 | 0 | 0 | 0 | -0.2 | -0.4 | 0.8 | – | 0 | 1.6 | 5.8 | 6.3 | 6.2 |
| Vacuole | 0 | 0 | 0 | 1.3 | 1.8 | 1.2 | 1.7 | 0 | 0 | – | 0 | 1.4 | 1.6 | 1.9 | 1.3 |
External localization resources
Images






























Protein Concentration and Protein Localization Data
| R1 | R2 | R3 | ||||||||||||||||
|---|---|---|---|---|---|---|---|---|---|---|---|---|---|---|---|---|---|---|
| G1 Pre-START | G1 Post-START | S/G2 | Metaphase | Anaphase | Telophase | G1 Pre-START | G1 Post-START | S/G2 | Metaphase | Anaphase | Telophase | G1 Pre-START | G1 Post-START | S/G2 | Metaphase | Anaphase | Telophase | |
| Concentration | 7.473 | 7.1773 | 6.4071 | 5.7559 | 5.9601 | 6.7164 | 7.5676 | 7.1462 | 6.5656 | 7.3165 | 5.9159 | 6.9241 | 6.4026 | 5.6983 | 5.6598 | 5.9469 | 5.3652 | 5.3707 |
| Actin | 0.0474 | 0.0066 | 0.0274 | 0.1195 | 0.0182 | 0.0215 | 0.0403 | 0.0082 | 0.0478 | 0.0586 | 0.0654 | 0.0069 | 0.0651 | 0.0089 | 0.0119 | 0.0066 | 0.0065 | 0.0193 |
| Bud | 0.0029 | 0.0055 | 0.0173 | 0.0058 | 0.0063 | 0.0034 | 0.0009 | 0.0014 | 0.0107 | 0.0043 | 0.0017 | 0.0024 | 0.0007 | 0.0028 | 0.0082 | 0.0112 | 0.0011 | 0.0011 |
| Bud Neck | 0.0169 | 0.0124 | 0.0604 | 0.0668 | 0.0614 | 0.1334 | 0.0111 | 0.0062 | 0.0429 | 0.0486 | 0.0132 | 0.1107 | 0.0152 | 0.0172 | 0.0511 | 0.0797 | 0.0838 | 0.1247 |
| Bud Periphery | 0.017 | 0.027 | 0.1845 | 0.0884 | 0.1146 | 0.0461 | 0.0045 | 0.005 | 0.1039 | 0.0907 | 0.0225 | 0.0279 | 0.0033 | 0.0084 | 0.0965 | 0.1756 | 0.019 | 0.019 |
| Bud Site | 0.0503 | 0.3667 | 0.1673 | 0.0158 | 0.0269 | 0.0083 | 0.0468 | 0.3875 | 0.1383 | 0.0192 | 0.0086 | 0.0074 | 0.0522 | 0.3899 | 0.1599 | 0.0047 | 0.0122 | 0.0019 |
| Cell Periphery | 0.5028 | 0.2952 | 0.3666 | 0.3657 | 0.5146 | 0.5096 | 0.5955 | 0.4151 | 0.4956 | 0.5852 | 0.5274 | 0.6276 | 0.5088 | 0.3439 | 0.5082 | 0.5498 | 0.4635 | 0.5225 |
| Cytoplasm | 0.2217 | 0.2598 | 0.0998 | 0.1498 | 0.0803 | 0.2244 | 0.1956 | 0.1647 | 0.0926 | 0.1628 | 0.1994 | 0.1807 | 0.2674 | 0.2009 | 0.1327 | 0.1379 | 0.2796 | 0.2762 |
| Cytoplasmic Foci | 0.0153 | 0.0005 | 0.0117 | 0.0232 | 0.0298 | 0.0031 | 0.0109 | 0.0002 | 0.0166 | 0.0026 | 0.0213 | 0.0061 | 0.012 | 0.0005 | 0.0008 | 0.0001 | 0.0045 | 0.0017 |
| Eisosomes | 0.0026 | 0.0006 | 0.003 | 0.0168 | 0.0005 | 0.0014 | 0.0025 | 0.0006 | 0.0008 | 0.0006 | 0.0081 | 0.0011 | 0.002 | 0.0042 | 0.0032 | 0.0001 | 0.0006 | 0.0005 |
| Endoplasmic Reticulum | 0.0292 | 0.0135 | 0.0102 | 0.018 | 0.0196 | 0.0158 | 0.0137 | 0.0038 | 0.0032 | 0.0047 | 0.0133 | 0.0094 | 0.0251 | 0.0077 | 0.0079 | 0.0197 | 0.0291 | 0.0148 |
| Endosome | 0.017 | 0.0006 | 0.0038 | 0.0167 | 0.0157 | 0.0055 | 0.0203 | 0 | 0.0021 | 0.0006 | 0.0161 | 0.0021 | 0.0094 | 0.0003 | 0.001 | 0 | 0.0104 | 0.001 |
| Golgi | 0.0089 | 0.0004 | 0.0034 | 0.0197 | 0.0087 | 0.0042 | 0.0065 | 0.0001 | 0.0045 | 0.0029 | 0.0388 | 0.0019 | 0.0073 | 0.0003 | 0.0006 | 0.0001 | 0.0107 | 0.0023 |
| Lipid Particles | 0.0105 | 0.0019 | 0.0021 | 0.0235 | 0.0207 | 0.0023 | 0.0081 | 0.0007 | 0.0068 | 0.002 | 0.018 | 0.0048 | 0.0034 | 0.0019 | 0.0017 | 0.0015 | 0.0393 | 0.0036 |
| Mitochondria | 0.0041 | 0.0001 | 0.0124 | 0.023 | 0.0055 | 0.0018 | 0.005 | 0 | 0.0007 | 0.0008 | 0.0058 | 0.0008 | 0.0008 | 0.0003 | 0.0001 | 0 | 0.0235 | 0.0017 |
| None | 0.0091 | 0.0004 | 0.0014 | 0.0013 | 0.0023 | 0.0023 | 0.0118 | 0.0006 | 0.0054 | 0.0011 | 0.0023 | 0.0011 | 0.0076 | 0.0008 | 0.002 | 0.0001 | 0.0005 | 0.0013 |
| Nuclear Periphery | 0.0097 | 0.0013 | 0.0018 | 0.0016 | 0.0028 | 0.0033 | 0.0101 | 0.0006 | 0.0017 | 0.0004 | 0.0011 | 0.0005 | 0.0087 | 0.001 | 0.0012 | 0.0009 | 0.0013 | 0.0004 |
| Nucleolus | 0.0014 | 0.0001 | 0.0035 | 0.0028 | 0.0009 | 0.0004 | 0.0005 | 0.0002 | 0.0011 | 0.0002 | 0.0001 | 0.0013 | 0.0002 | 0.0008 | 0.0002 | 0.0001 | 0.0003 | 0.0001 |
| Nucleus | 0.0079 | 0.0009 | 0.0028 | 0.0018 | 0.0015 | 0.0026 | 0.0033 | 0.0007 | 0.0019 | 0.0007 | 0.0004 | 0.0007 | 0.001 | 0.0009 | 0.0012 | 0.0006 | 0.0005 | 0.0006 |
| Peroxisomes | 0.0059 | 0 | 0.0095 | 0.0205 | 0.051 | 0.0012 | 0.0053 | 0 | 0.0103 | 0.0023 | 0.0327 | 0.0009 | 0.0015 | 0.0001 | 0 | 0 | 0.005 | 0.0023 |
| Punctate Nuclear | 0.0053 | 0.0001 | 0.0007 | 0.0007 | 0.0068 | 0.0006 | 0.0023 | 0.0001 | 0.0077 | 0.0001 | 0.0005 | 0.0004 | 0.0011 | 0.0001 | 0.0002 | 0 | 0.0003 | 0.0002 |
| Vacuole | 0.0128 | 0.0062 | 0.0099 | 0.0151 | 0.0115 | 0.0075 | 0.0046 | 0.0043 | 0.0052 | 0.0113 | 0.0031 | 0.0054 | 0.0067 | 0.009 | 0.0111 | 0.011 | 0.0078 | 0.0047 |
| Vacuole Periphery | 0.0011 | 0.0002 | 0.0004 | 0.0034 | 0.0003 | 0.0011 | 0.0007 | 0 | 0.0001 | 0.0001 | 0.0002 | 0.0001 | 0.0006 | 0.0001 | 0.0002 | 0.0001 | 0.0009 | 0.0001 |
Sequencing Data
| R1 | R2 | |||||||||
|---|---|---|---|---|---|---|---|---|---|---|
| G1 Post-START | S/G2 | Metaphase | Anaphase | Telophase | G1 Post-START | S/G2 | Metaphase | Anaphase | Telophase | |
| Gene Expression | 13.9924 | 32.1644 | 18.5635 | 20.5625 | 12.9584 | 19.9781 | 17.6158 | 18.2915 | 19.096 | 17.9601 |
| Translational Efficiency | 2.1994 | 1.2518 | 1.7294 | 2.2528 | 2.6976 | 1.4791 | 2.0592 | 2.102 | 2.0876 | 1.7182 |
Hit Data
| Dataset | Hit |
|---|---|
| Protein Concentration | ✘ |
| Protein Localization | ✔ |
| Gene Expression | ✘ |
| Translational Efficiency | ✘ |
Endocytosis
| Temp | Actin Patch (Sac6-tdTomato) | Cortical Patch (Sla1-GFP) | Late Endosome (Snf7-GFP) | Vacuole (Vph1-GFP) |
|---|---|---|---|---|
| 37℃ | ||||
| RT |
Cell Cycle Omics
CYCLoPs (Arf3-GFP)
| Gene / Allele | Actin Patch (Sac6-tdTomato) | Cortical Patch (Sla1-GFP) | Late Endosome (Snf7-GFP) | Vacuole (Sac6-tdTomato) |
|---|
| Gene | Images |
|---|
| Gene | Images |
|---|
Images are not yet available
Images are not yet available